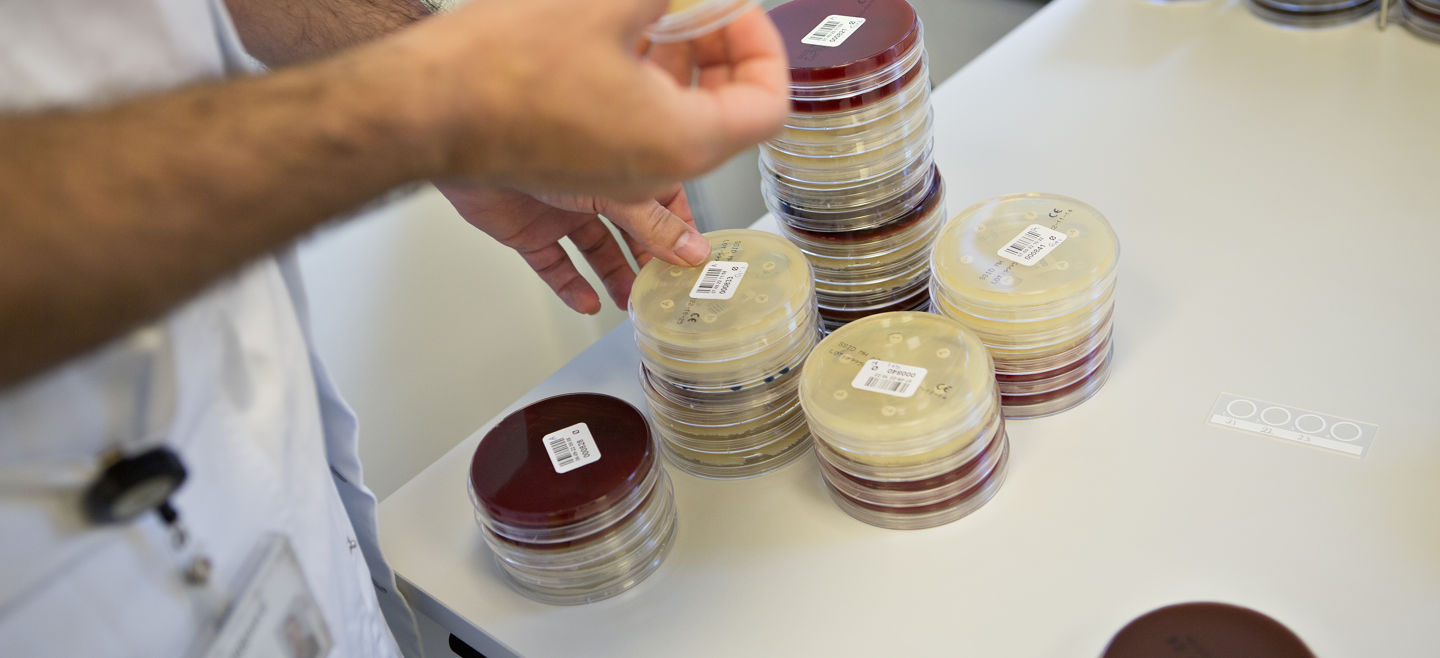

Impact of Measles, Mumps, and Rubella Vaccination on Hospitalizations and Human Capital: Evidence from Copenhagen School Health Records
Udgivelsens forfattere:
- Onur Altindag
- Jane Greve
- Erdal Tekin
Sundhed
Dagtilbud, skole og uddannelse
Sundhed, Dagtilbud, skole og uddannelse
I 1987 blev vaccine mod mæslinger, fåresyge og røde hunde (MFR) indført i det danske børnevaccinationsprogram. Medicinsk litteratur har tidligere peget på, at særligt mæslingevaccine kan have gavnlige ikke-specifikke effekter. Ikke-specifikke effekter er effekter, som ikke er direkte relateret til de sygdomme, vaccinen beskytter i mod. I denne artikel undersøger vi, om MFR-vaccine på længere sigt kan have gavnlige effekter på uddannelse og beskæftigelse – altså effekter ud over selve effekten ved at reducerede de sygdomme, som vaccinen beskytter mod. Til at undersøge dette fokuserer vi på perioden før og efter introduktionen af MFR-vaccine i det danske børnevaccinationsprogram og undersøger forskelle i vaccinestatus mellem søskende, da vi derved kontrollerer for familie-specifikke faktorer.
Resultaterne peger på en moderat effekt af vaccinen på uddannelse, herunder sandsynligheden for at have færdiggjort grundskolen. Dette gælder dog kun for dem, som blev vaccineret før 1987, dvs. før der er flokimmunitet i befolkningen.
Resultaterne peger på, at det ikke er vaccinen i sig selv, men i højere grad det ikke at få mæslinger, som driver de ikke-specifikke effekter.
Resultaterne bekræfter tidligere undersøgelser af ikke-specifikke effekter af MFR-vaccine og understreger yderligere gevinster ved at indføre denne vaccine i et børnevaccinationsprogram, således at der opnås flokimmunitet og alle får gavn af både specifikke og ikke-specifikke effekter.
Udgivelsens forfattere
Om denne udgivelse
Samarbejdspartnere
Novo Nordisk FondenPubliceret i
Vaccines (Basel)